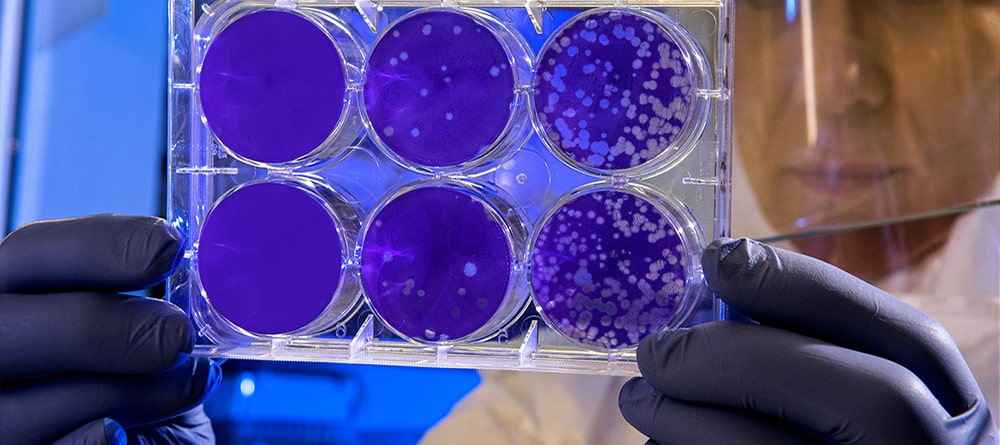

The Jamjoom family has been deeply involved in the pharmaceutical sector since the 1950s, driven by a mission to serve the nation with high-quality pharmaceuticals and play a responsible role in improving public health. Our journey began with a commitment to addressing the healthcare needs of our community, and over the decades, it has evolved into a dynamic and visionary enterprise.
We have grown beyond providing essential medicines to champion the localization of pharmaceutical manufacturing in Saudi Arabia. At Jamjoom Pharma, we are proud to contribute to the healthcare sector’s self-reliance by producing world-class products within the region, fostering innovation, and creating lasting value for our society.